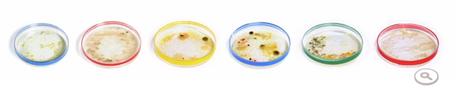
doodle google julius richard petri

Hace unas horas Google actualizó su famoso Doodle rindiendo un homenaje al 161º aniversario del nacimiento de Julius Richard Petri.
Hace unas horas Google actualizó su famoso Doodle rindiendo un homenaje al 161º aniversario del nacimiento de Julius Richard Petri.
Julius Richard Petri, fue un científico alemán, más concretamente microbiólogo, que inventó las placas que llevan su nombre (placas de Petri) con las que consiguió aislar bacterias.
Estos cristales o cápsulas redondas son muy utilizadas en todos los laboratorios del mundo y facilitaron mucho la labor de los científicos. Además de aislar bacterias permiten establecer un campo de cultivo y estudiar su comportamiento.
Sobre el Doodle
Los Doodle de Google son imágenes con animación que el buscador más famosos del mundo lleva haciendo desde hace unos años y mostrando en el lugar de su logo. Al final de esta animación se muestran la letras de Google de una u otra forma como podemos ver en este caso en las placas de Petri.
Puedes saber más sobre este genial científico en este enlace y más sobre el Doodle en la gran entrada de La Voz de Galicia.
La entrada Julius Richard Petri – Doodle del día se publicó primero en Borja Girón.
